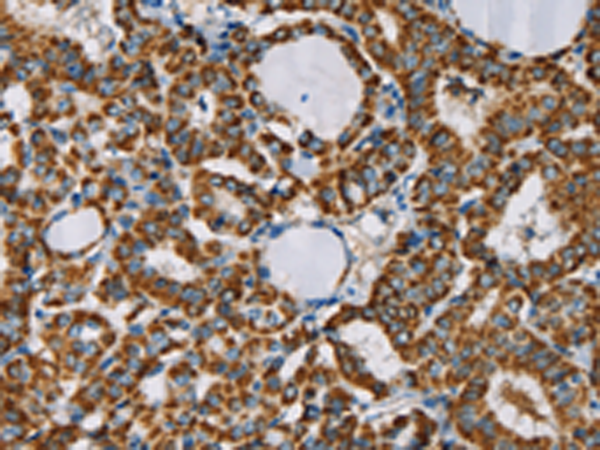

-
分类: 科研抗体货号: P08528别名: p8; C6.1B; MTCP1; MTCP1B; MTCP1NB; p8MTCP1应用: IHC反应种属: Human, Mouse
-
分类: 科研抗体货号: P08511别名: NYD-sp9应用: IHC反应种属: Human, Mouse, Rat
-
分类: 科研抗体货号: P08492别名: CT1.10; MAGE10应用: WB,IHC反应种属: Human
-
分类: 科研抗体货号: P08527别名: MIMP; HSPC032; SLC25A50应用: WB,IHC反应种属: Human, Mouse
-
分类: 科研抗体货号: P08510别名: NRMT; NTM1A; AD-003; HOMT1A; C9orf32; METTL11A应用: IHC反应种属: Human, Mouse, Rat
-
分类: 科研抗体货号: P08491别名: BBS17应用: WB,IHC反应种属: Human, Mouse, Rat
-
分类: 科研抗体货号: P08526别名: S7; MSS1; Nbla10058应用: WB,IHC反应种属: Human, Mouse, Rat
-
分类: 科研抗体货号: P08509别名: PAB1; PABP; PABP1; PABPC2; PABPL1应用: WB反应种属: Human, Mouse, Rat
-
分类: 科研抗体货号: P08490别名: JTK8; p53Lyn; p56Lyn应用: IHC反应种属: Human, Mouse, Rat
-
分类: 科研抗体货号: P08525别名: SRA; SR-A; CD204; phSR1; phSR2; SCARA1应用: IHC反应种属: Human, Mouse

鄂公网安备42018502007531号
鄂公网安备42018502007531号

